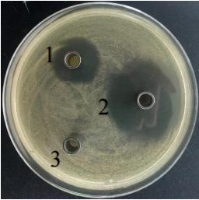
image.png

生物源股份“净念康”获国家发明专利授权!阅读次数 [6612] 发布时间 :2022-08-30
作者:祁姣姣 审核:朱剑锋,胡文锋

日前,生物源股份为主申请的“一种防治白色念珠菌病的组合物及含有该组合物的药物和饲料添加剂”发明专利获得国家知识产权局授权,专利号:ZL202010251799.7。
本发明提供了一种防治白色念珠菌病和霉菌感染的组合物及含有该组合物的药物和饲料添加剂。组合物包含植物精油,植物提取物,益生菌代谢产物。
基于该专利技术研制的“净念康”产品已经上市两年多,已在多家养禽公司应用和推广,可有效针对禽类白色念珠菌和霉菌等真菌感染,以及相关致病细菌感染疾病,增强家禽免疫力,维持群体健康稳态,增加养殖经济效益,是养殖企业提升生物安全的新思路。

本发明所述的技术是由生物源股份联合华南农业大学、温氏食品集团养禽事业部的禽病室联合开发的,在抗菌天然物质筛选、抗菌组合物优化以及肉鸽攻毒保护等方面做了详实的研究,为“净念康”产品开发与应用推广奠定基础。相关研究成果发表于核心期刊《中国家禽》。以下是关键试验结果展示*。
1. 体外抗鸽源白色念珠菌(以下同)效果的比较
1.制霉菌素;2.柑橘油与百里香油组合;3.DMSO(助溶剂)。
图1 植物精油组合对白色念珠菌的抑制作用
由图1可知,0.8%柑橘油与百里香油组合抑菌圈直径为32.08mm,0.8%制霉菌素的抑菌圈直径23.15mm,表明0.8%柑橘油与百里香油组合对白色念珠菌的抑制效果优于0.8%制霉菌素。
1. 不同处理时间对白色念珠菌细胞形态的影响


a.对照组 b.0.5h


c.1h d.2h
a.0.8%制霉菌素;b、c和d 0.8%的柑橘油和与百里香酚组合试剂
图2 0.8%柑橘油和百里香油组合处理白色念珠菌对细胞形态的影响(10000×)
由图2可知,a(对照组):白色念珠菌菌体形态圆润饱满,还能看出其厚膜孢子结构。
b:处理0.5h后,试验组白色念珠菌的芽管断裂,假菌丝皱缩扁平;菌体完全破裂,胞内物质流出,只剩破裂的细胞壁和细胞膜;
c:处理1h后,白色念珠菌菌体表面多处破裂,细胞内物质完全流出导致细胞扁平,甚至可以看到细胞壁和细胞膜的断层;
d:处理2h,假菌丝断裂,菌体表面出现皱褶。
小结:经0.8%柑橘油和百里香油组合处理,菌体均会出现破裂,胞内物质流出,假菌丝断裂等现象,因此会导致白色念珠菌死亡。
1. 肉鸽攻毒保护试验
表1 不同处理组患病鸽嗉囊状况
组别 | 处理方式 |
试验组 | 灌喂200uL净念康,共两次 |
对照组 | 不做灌喂治疗处理 |

图3 组合物处理后患病鸽嗉囊解剖病变情况
由图3可知,试验组在一个处理过程后,肉鸽精神良好,采食和饮水恢复正常;而对照组可见白色念珠菌临床症状,仍然发现白色伪膜。
为验证白色念珠菌伪膜是否恢复,故间隔一天剖杀。解剖嗉囊发现,嗉囊洁净,无白色伪膜;经过微生物分离、鉴定没有分离到白色念珠菌。故试验组鸽子灌胃0.8%柑橘油与百里香油组合后,鸽嗉囊恢复正常,并未发现白色念珠菌感染症状。
*注:郭罕星,王占新,鲁俊鹏,覃健萍,祁姣姣,胡学生,元波,陈彤,房向杰,胡文锋.植物精油对鸽源白色念珠菌的体外抑菌作用及肉鸽攻毒保护试验[J].中国家禽,2020,42(09):47-53.DOI:10.16372/j.issn.1004-6364.2020.09.008.